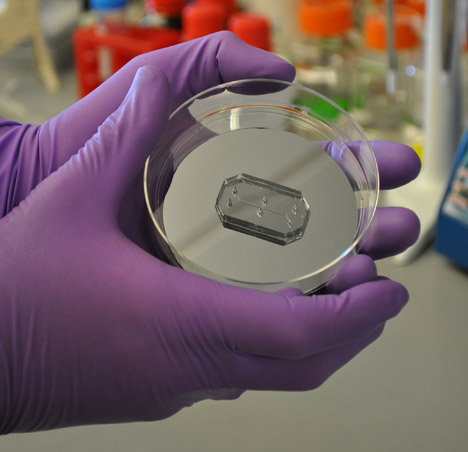

Un microchip vince il Design of the Year 2015. Il Design Museum di Londra premia Human Organ-on-Chips, dispositivo che mima gli organi umani
È un microchip con cellule umane integrate che mima il comportamento dei nostri organi il vincitore assoluto del Design of the Year 2015, il premio conferito dal Design Museum di Londra ai progetti che, annualità dopo annualità, si distinguono per innovazione funzionale, estetica, sociale. Human Organ-on-Chips, questo il nome dell’inedito prodotto, è stato sviluppato da […]

È un microchip con cellule umane integrate che mima il comportamento dei nostri organi il vincitore assoluto del Design of the Year 2015, il premio conferito dal Design Museum di Londra ai progetti che, annualità dopo annualità, si distinguono per innovazione funzionale, estetica, sociale. Human Organ-on-Chips, questo il nome dell’inedito prodotto, è stato sviluppato da due ricercatori, Donald Ingber e Dan Dongeun Huh dello Wyss Institute di Harvard. Non due designer di professione, quindi, sebbene Deyan Sudjic, direttore del museo londinese, abbia tenuto a precisare che questo “non gli abbia impedito di sviluppare un brillante pezzo di design”.
Quali le applicazioni possibili? Già dobbiamo intravedere un futuro senza trapianti e ricerche sulle staminali? Andiamoci piano. Human Organs-on-Chips sarà utilizzato in un primo momento per la sperimentazione di farmaci e cosmetici, evitando il coinvolgimento di animali nelle attività di ricerca. Oltre al progresso scientifico, però, il premio è indicativo anche di un cambio di rotta nelle preferenze della giuria: dopo la vittoria nel 2014 dello Heydar Aliyev Center di Baku, il mastodontico centro culturale firmato Zaha Hadid, ad aggiudicarsi il premio dei premi è progetto di piccolissima scala, eppure votato ad un progresso di grandi proporzioni fortemente legato all’innovazione scientifica.
– Giulia Zappa
Artribune è anche su Whatsapp. È sufficiente cliccare qui per iscriversi al canale ed essere sempre aggiornati